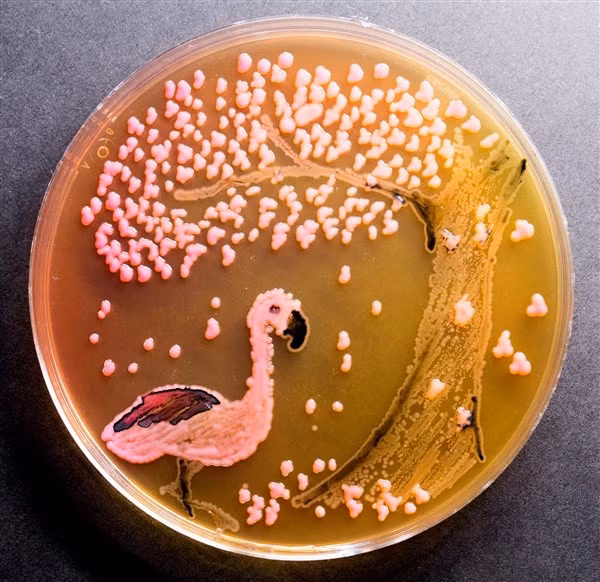
Táo bạo tranh vẽ bằng vi khuẩn ảnh 1

Song có một số nhà khoa học làm việc trong phòng thí nghiệm có sở thích sáng tác tranh bằng vi khuẩn, nấm mốc hay địa y… mà tạo nên một nghệ thuật độc đáo, gọi là Germ Art hay Agar Art.
Nghệ thuật này đã có từ lâu đời, mà người tiên phong trong lĩnh vực ấy là nhà sinh học Scotland - ông Alexander Fleming (1881 - 1955), người đã tìm ra thuốc kháng sinh penicillin và đoạt giải Nobel năm 1945.
Từ nhỏ, Alexander Fleming đã thích nuôi cấy vi khuẩn, dùng các loài nấm, chất nhờn bã đã lên men lâu ngày để vẽ ra những bức tranh sặc sỡ, ấn tượng trước khi thành một thầy thuốc. Do am hiểu về nhiều loại vi khuẩn, nhiều thể nấm khi ký sinh trên “thức ăn” sẽ phát triển và nảy sinh màu sắc thế nào, nên ông đã cho ra đời khá nhiều tác phẩm hội họa, mang nội dung phong phú - hấp dẫn.
Ông đã đưa nghệ thuật vào trong khoa học, làm nên sự giao thoa tuyệt mỹ. Ở đó, những ống hút là bút vẽ, còn những đĩa cạn nuôi cấy vi khuẩn là giá vẽ, trong khi màu và mảng miếng trong tranh chính là thạch trắng cùng những vi sinh vật đơn bào.
Kế thừa ông, đến nay đã có hàng trăm, hàng nghìn người biết vẽ tranh này và tham dự các cuộc thi vẽ bằng vi khuẩn trong nước lẫn quốc tế, với đa dạng đề tài từ phong cảnh tới tĩnh vật, chân dung...
Nói chung, để sáng tác Germ Art không khó, nhưng cũng không dễ. Ngoài các dụng cụ cần thiết thuộc phòng la bô như pipettes (ống hút), petri dishes (đĩa cạn), microscope (kính hiển vi), agar-agar (thạch trắng)… họa sĩ còn cần một kiến thức về sinh học.
Tức là các loại vi khuẩn (microbes), nấm, tảo và quá trình lên men nhờ chúng (mỗi loại tương ứng một màu). Muốn có hai, ba màu thì cần hai, ba loại vi khuẩn và hay được dùng nhất để vẽ tranh là vi khuẩn Bacillus subtilis cho màu trắng kem cho nâu. Vi khuẩn Cladosporium herbarum cho màu nâu tới đen. Vi khuẩn Micrococcus luteus cho màu vàng tươi.

Vi khuẩn Micrococcus roseus cho màu hồng phấn. Vi khuẩn Serratia marcescens cho màu da cam. Vi khuẩn Epicoccum nigrum cho màu đỏ thắm. Vi khuẩn Euglena gracilis cho màu xanh lá. Vi khuẩn Pseudomonas fluorescense cho màu xanh lam song có huỳnh quang…
Tuy các con nguyên sinh bào này cho màu sắc rất tươi, tự nhiên song để lên tranh đẹp cũng cần phải có sự hỗ trợ của tia cực tím (tử ngoại) chiếu vào chúng, giúp chúng phát sáng.

Một bức tranh đẹp dĩ nhiên cũng phải có nội dung và bố cục đẹp, và cái này chỉ có người có năng khiếu hội họa mới làm nổi, hay nói tóm lại phải biết vẽ mới đẹp. Vì các bức tranh đều khá nhỏ nên phần lớn quy trình thực hiện đều được diễn ra dưới kính hiển vi.
Kết quả sau cùng có thể được xem trực tiếp qua những cái đĩa xinh xắn, song đa số đều được chụp lại bằng máy ảnh để lưu giữ thành quả lâu dài. Do chỉ cần vượt quá vài ngày các loại vi khuẩn, nấm mốc, rêu tảo trên đĩa (thạch trắng) sẽ nảy nở quá mức, biến màu, biến hình, phá vỡ bố cục.

Khác với những bức tranh thông thường mỗi ngày chỉ vẽ được một vài bức, Germ Art thường không giới hạn số lượng, vì có thể làm hàng loạt trên các đĩa cạn có sự nuôi cấy vi khuẩn khác nhau.
Song với các họa sĩ cầu kỳ, họ thường chỉ tập trung vào một sáng tác nhằm có được thành quả mỹ mãn, để trưng bày cũng như dự thi dành giải thưởng. Hiện tại, một nơi tổ chức thi vẽ tranh bằng vi khuẩn được nhiều người hưởng ứng nhất là Hội Vi khuẩn học ASM của Mỹ.

Từ năm 2014, ở đây đã có cuộc thi thường niên dành cho cả các nhà khoa học (chuyên gia) lẫn người yêu vẽ và trẻ em nhằm giúp mọi người khám phá vẻ đẹp của tự nhiên, phát huy sức sáng tạo, tưởng tượng. Bởi vì thế giới vi khuẩn là một vũ trụ rất là mới lạ, huyền diệu.





































